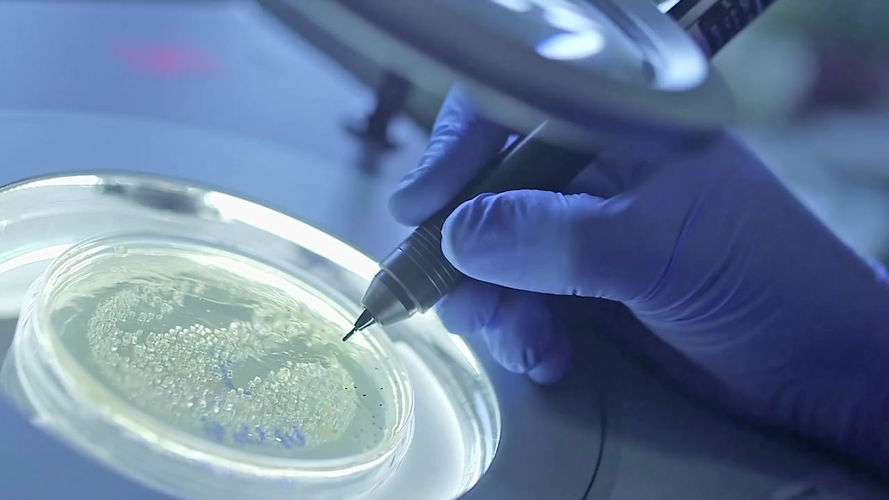

top of page
ABOUT US WE ARE THE
TRUSTED EXPERTS
At Axis Clinical Laboratory, we utilize cutting-edge molecular testing methods to rapidly identify multiple bacterial and viral pathogens, as well as key antimicrobial resistance markers, directly from patient samples, enabling accurate, same-day results to support precise clinical decision-making.

Precision Diagnostics, Powered by Innovation
Our laboratory is equipped with cutting-edge molecular platforms and operated by experienced professionals dedicated to diagnostic innovation and integrity.
Our Expert Team
Our expert team brings together experience and innovation, ensuring accurate results with a strong commitment to patient care.
.jpg)
Head Microbiologist
Alex Mitchell
.jpg)
Laboratory Technician
Samantha Wood
.jpg)
Senior Рathologist
Matthew Atkins
bottom of page

